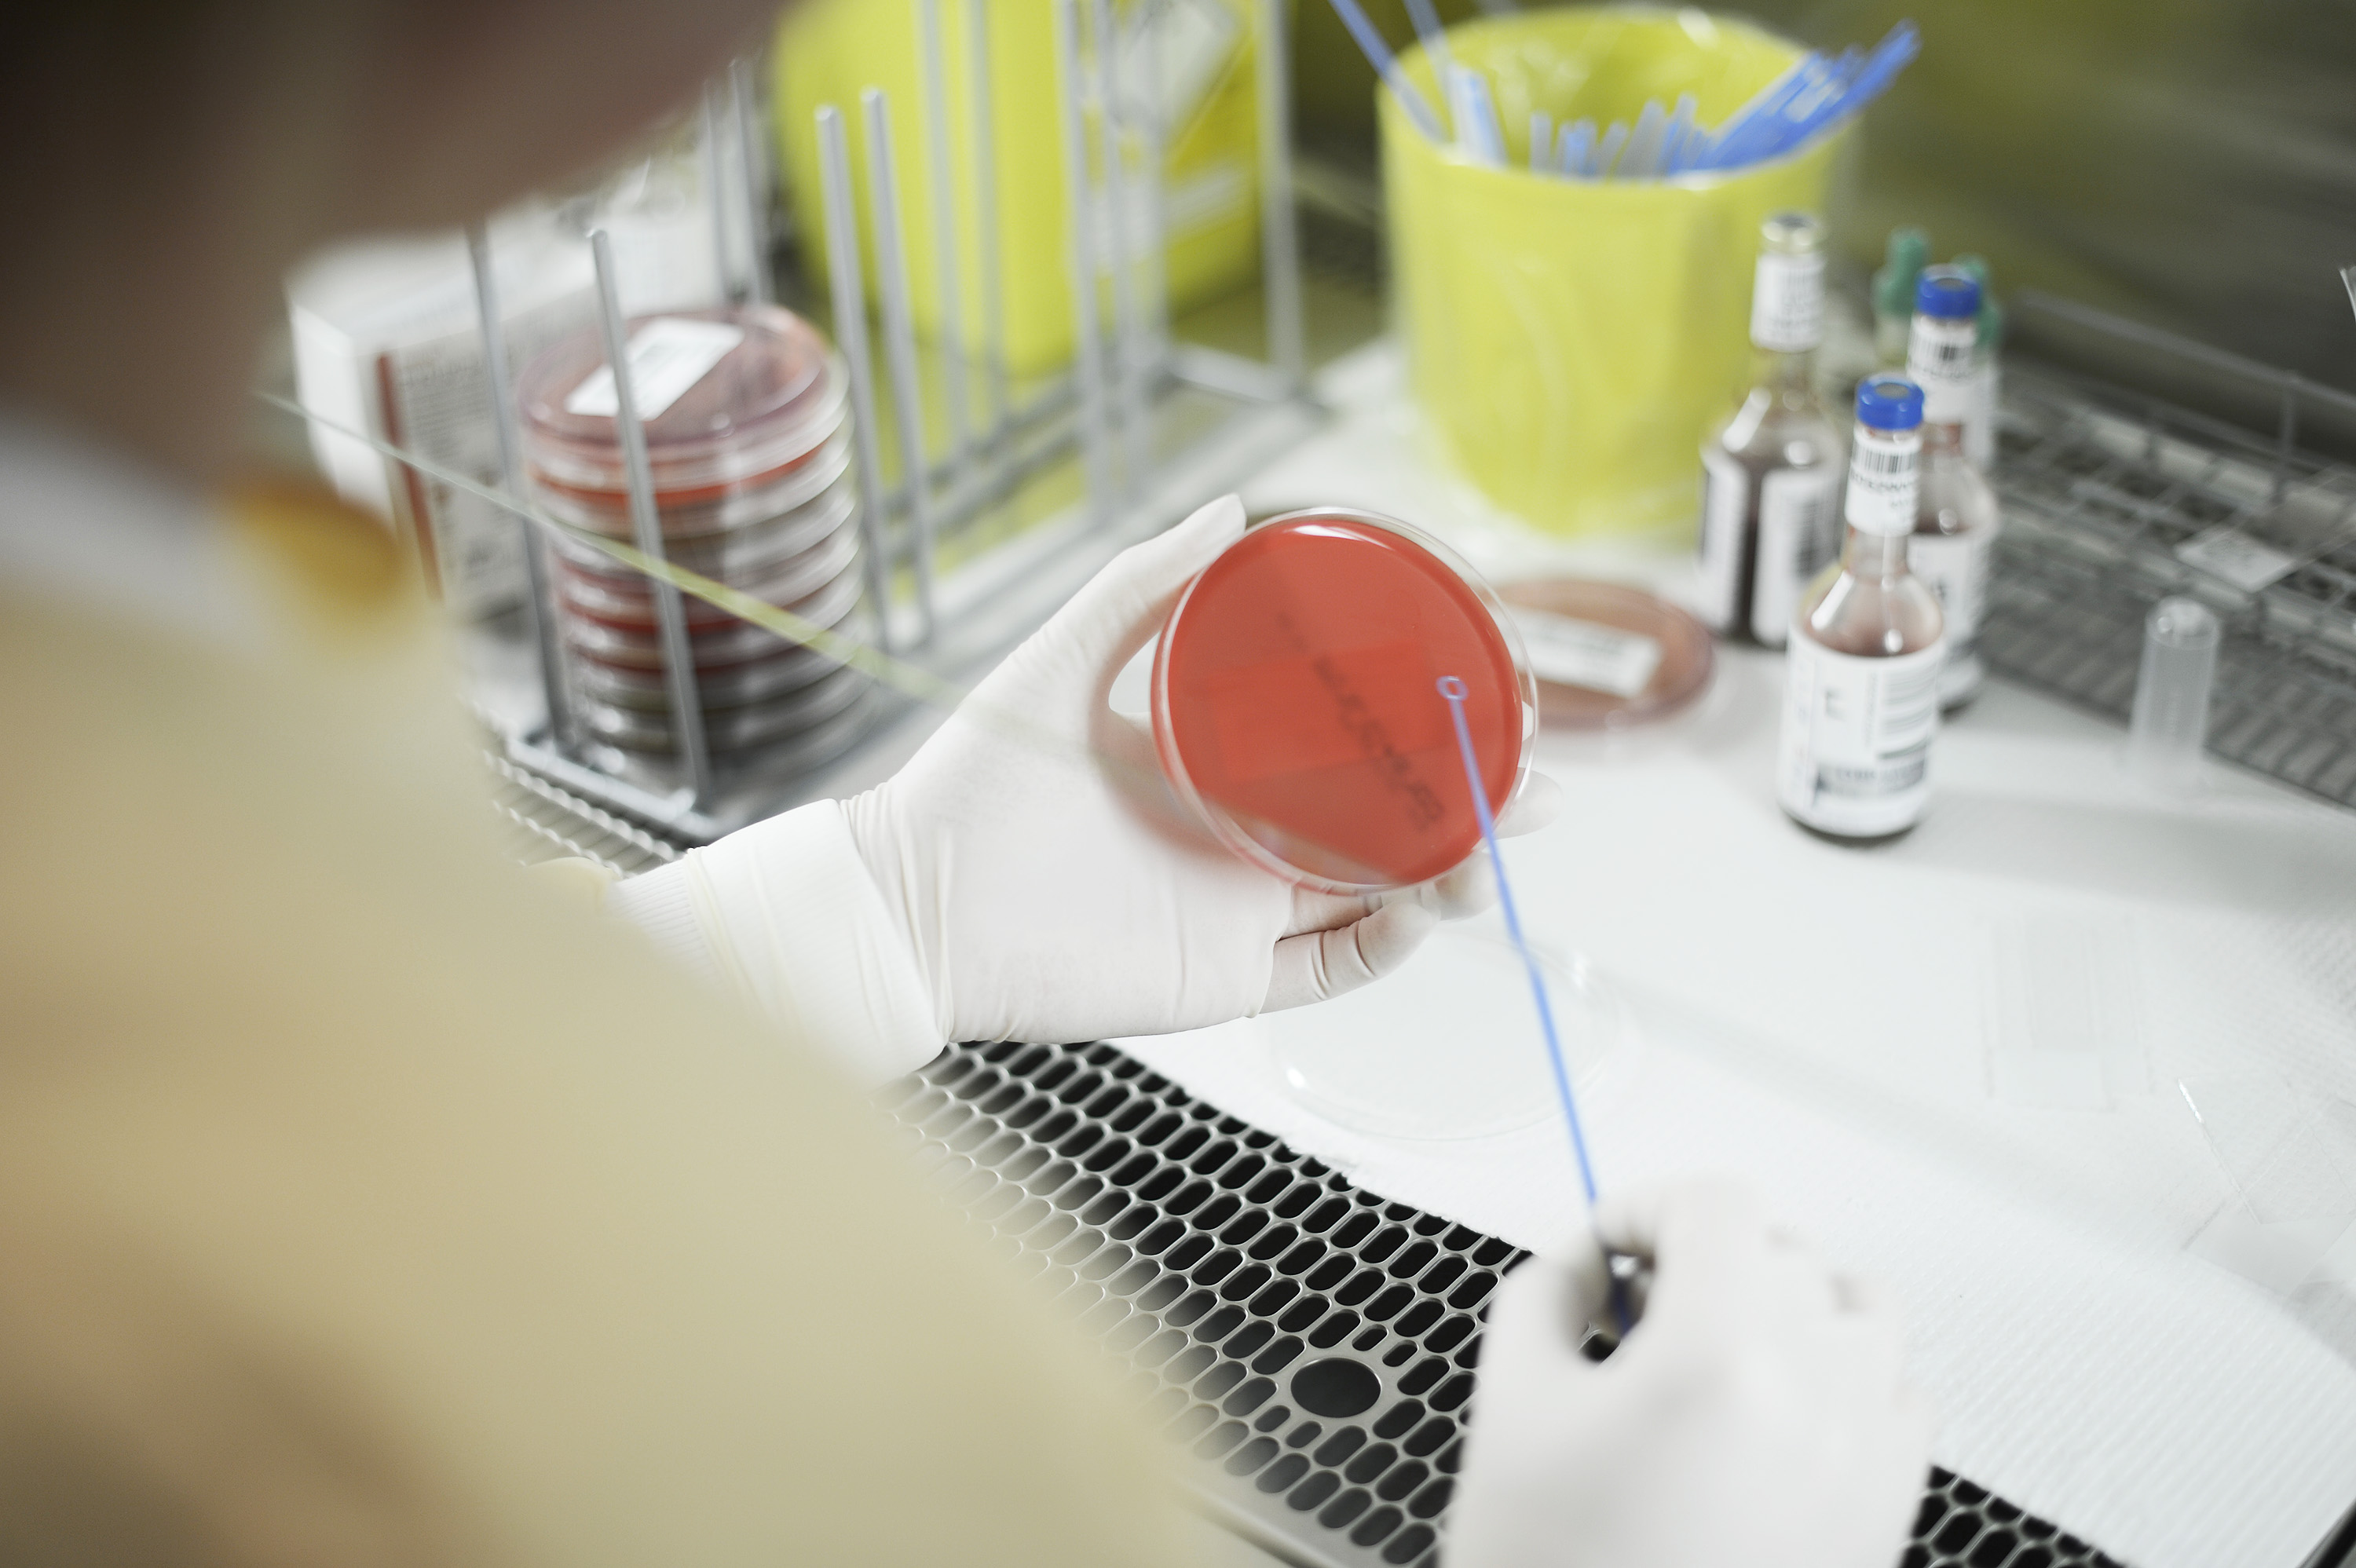
Nærbilde av hender som bruker laboratorieutstyr

Forsking og innovasjon
Forskingsstrategi
Helse Fonna skal ha forsking og innovasjon av god kvalitet i alle kliniske einingar.
Forsking og innovasjon i Helse Fonna skal bidra til
Robuste fagmiljø som gir gode spesialisthelsetenester
Tenester tilpassa pasientane sine behov
Å styrke Helse Fonna sitt omdøme
Å rekruttere og ta vare på dyktige helsepersonell og forskarar
Stoltheit over å arbeide i Helse Fonna
At vi blir ein samarbeidspartner for andre forskingsinstitusjonar lokalt, regionalt og nasjonalt
Brukarmedverknad i alle forskings- og innovasjonsprosjekt.
Visjon
Fremme helse, meistring og livskvalitet gjennom forsking og innovasjon av god kvalitet.Fremme helse, meistring og livskvalitet gjennom forsking og innovasjon av god kvalitet.
Helse Fonna skal ivareta ansvaret for forsking i tråd med lovar og nasjonale, regionale og lokale føringar[1]. Vi skal vidareutvikle eit inkluderande, kompetent og anerkjent forskingsmiljø med tydeleg leiing, tettare integrasjon mellom klinikk og forsking, og god infrastruktur.
I tråd med nasjonale føringar skal føretaka legge til rette for å leie og å delta i kliniske behandlingsstudiar[2]. Dette stiller krav til eit godt samarbeid mellom forsking, klinikk og støttetenester.
[1] Spesialisthelsetenestelova, Nasjonal helse- og sjukehusplan, Helse og Omsorg 2020, Helse 2035 Strategi Helse Vest, Strategi for forsking og innovasjon i Helse Vest 2020-2023 og Helse Fonna sin utviklingsplan
[1] St.mld. 28, Helse Vest forskingsstrategi og Styringsdokument
Det er et ledelsesansvar å legge til rette for at forskning inngår som en integrert del av pasientbehandlingen, at tid til klinikk balanseres mot tid til klinisk forskning, og sørge for støttepersonell og at det skapes en kultur og et handlingsrom for klinisk forskning og annet utviklingsarbeid.Nasjonal helse- og sjukehusplan 2020-2023
Eit satsingsområde for forsking og innovasjon er samhandlinga mellom kommunehelsetenesta og spesialisthelsetenesta. Vi treng meir kunnskap om korleis pasientane skal få heilskaplege tenester tilpassa behova dei har.
Ifølgje nasjonal helse- og sjukehusplan skal det etablerast helsefellesskap der sjukehus og kommunar skal ha betre samarbeid om dei mest sårbare pasientane, der fire pasientgrupper skal prioriterast:
Personar med alvorlege psykiske lidingar og rusproblem
Skrøpelege eldre
Barn og unge
Personar med fleire kroniske lidingar
I tilknyting til desse helsefellesskapa skal det utviklast samarbeid om forsking.
Helse Fonna skal utnytte innovasjonspotensialet som følgje av forsking. Vi skal særleg vektlegge innovasjon som bidreg til ny behandling, nye måtar å gi tenester på.
Samarbeid mellom kliniske einingar, forsking- og innovasjonsmiljø og andre aktørar i kommunane er sentralt for utvikling av helsetenestene. Næringslivet sit på kompetanse som bør kome pasientane til gode gjennom samarbeid med Helse Fonna.
Forsking og innovasjon skal bidra til å gjere helsetenesta verksam, effektiv og nytenkande. Helse Fonna skal byggje ein innovasjonskultur som fremmer deling av gode idear og utvikling av nye løysingar på eksisterande og nye utfordringar på tvers av klinikkar og avdelingar.
Helse Fonna skal kunne vedlikehalde og auke sin forskings- og innovasjonsaktivitet og utvikle forsking og innovasjon frå primært å utdanne forskarar til å bli ein robust forskingsinstitusjon.
Fremme helse, meistring og livskvalitet gjennom forsking og innovasjon av god kvalitet.
Klikknær forsking og innovasjon
Helse Fonna sitt hovudfokus skal vere helseteneste- og klinikkretta forsking og innovasjon som kjem pasientar og pårørande til gode.
Godt samarbeid med kliniske einingar, delte stillingar mellom klinikk og forsking og kunnskapsutveksling mellom kliniske avdelingar og forskarar skal gi forsking med høg grad av klinisk relevans og bidra til fagutvikling i klinikkane. Dette vil også styrke kunnskapsgrunnlaget for god pasientbehandling.
Synleggjering av forsking, forskingsfagleg rettleiing, delte stillingar mellom forsking og klinikk og tematiske forskingsgrupper skal stimulere rekrutteringa og oppretthalde forskingskompetansen i føretaket.
Mål: Styrke samhandling mellom klinikk og forsking
Tiltak 1: Årsrapportering av forsking og innovasjon til føretaksleiing og styret (i september)
Tiltak 2: Klinikkvis årleg gjennomgang av pågåande forskings- og innovasjonsprosjekt med direktørane. Tilby presentasjon av Forskings- og innovasjonsavdelinga, presentasjon av forskarar og formidling av aktuelle forskingsresultat i avdeling/klinikk.
Tiltak 3: Samlokalisere forsking og klinikk. Legge til rette for lokale og infrastruktur for å ivareta pasientar som deltar i kliniske forskingsstudiar.
Kliniske studiar som inkluderer pasientar krev at det er tilgjengeleg biobank, laboratorie- og radiologitenester. Kapasitet og organisering av desse tenestene skal styrkast i denne planperioden.
Mål: Styrke kompetanse og auke kapasitet og tilgjengelegheit for forskning i laboratorie og radiologi i føretaket
Tiltak 1: Etablere insitament og kompetanseheving i dedikerte stillingar ved laboratoriet og radiologisk avdeling.
Tiltak 2: Etablere infrastruktur og rutinar for biobankar i forskingsprosjekt.
I tråd med nasjonale føringar skal vi legge til rette for kliniske behandlingsstudiar som gir pasientar moglegheit for utprøvande behandling.
Føresetnadar for å auke talet på kliniske behandlingsstudiar er samarbeid med dei kliniske einingane og tilrettelagte medisinske støttetenester frå laboratoria (inklusiv tilrettelegging for biobank) og bildetenester frå radiologisk avdeling.
Kapasitet, organisering og opplæring av støttetenester for kliniske behandlingsstudiar skal prioriterast i denne planperioden.
Mål: Helse Fonna skal vere hovudsøkar eller medverke som aktiv forskingspartnar i minst åtte regionale og nasjonale forskingssøknadar per år. Det skal til ei kvar tid vere seks pågåande kliniske behandlingsstudiar..
Tiltak 1: Etablere rutinar og retningsliner saman med klinikkdirektørar for vurdering og inngåing av avtalar om kliniske behandlingsstudiar
Tiltak 2: Avtale med bemanningssenteret om tilsetting og opplæring av forskingssjukepleiarar og tilsetting av forskingskoordinator
Tiltak 3: Retningsliner på føretaksnivå som gir nødvendige støttetenester tilgjengeleg for kliniske behandlingsstudiar, for eksempel radiologi og laboratorietenester
Innovasjon i Helse Fonna skal gi betre helsetenester for pasientar gjennom ny eller betra utgreiing, behandling, pasientforløp eller organisering av tenestene. Innovasjon skal bidra til å løyse dei problema som helsetenesta møter i framtida.
Forsking og innovasjon bidrar til å gjere helsetenesta verksam, effektiv og nytenkande. Ein god kultur for innovasjon bidrar til at tenestene blir utvikla basert på behov og at gode løysingar blir synleggjort, delt og tatt i bruk. Dette krev god infrastruktur og tett samarbeid mellom forsking- og innovasjonsavdeling, kliniske einingar, brukarorganisasjonar og andre samarbeidspartnarar, mellom anna i næringslivet.
Mål: Ein innovasjonskultur som bidrar til at tenestene blir utvikla basert på behov og at gode løysingar blir synleggjort, delt og tatt i bruk
Tiltak 1: Prioritering av innovasjonar med utgangspunkt i utviklingsplan og klinikkane sine behov gjennom presentasjon av prosjekta i Strategisk forum for innovasjon og IKT
Tiltak 2: Avklare organisatoriske forhold, ansvar og retningsliner for innovasjonsområdet
Tiltak 3: Avklare moglege samarbeidspartnarar for innovatørar på eit tidleg tidspunkt, irekna regionale funksjonar i Helse Vest, innovasjonsavdelinga ved Helse Vest IKT, InnoMed og TTO
Tiltak 4: Legge til rette for å ta i bruk ulike verktøy som innovasjonscamp, «Nyskapingsklinikk» og TEKprat med aktuelle aktørar og næringsliv i regionen

Frå utdanningsinstitusjon til robust forskingsinstitusjon
Forsking og innovasjon er avhengig av finansiering som er føreseieleg, stabil og langsiktig. Helse Fonna vil ha som mål at delen av totalbudsjettet som går til forsking gradvis blir auka i tråd med nasjonale føringar. Forsking og innovasjon blir finansiert gjennom basis-finansiering i føretaket og ved at forskarane vinn fram med søknadar om eksterne forskings- og innovasjonsmidlar.
Ein del forskingsprosjekt, kliniske studiar og innovasjonsprosjekt krev juridisk avtalekompetanse, tilrettelegging av budsjettplanlegging og rekneskapsoppfølging, samt HR-tenester knytt til personal- og tilsettingsforhold i prosjekta.
Mål: Forsking i alle kliniske einingar
Tiltak 1: Føretaket skal ha som mål at delen av totalbudsjettet som går til forsking gradvis blir auka i tråd med nasjonale føringar.
Tiltak 2: Auke talet på tilgjengelege forskingsstillingar, interne postdoc- og PhD-stipend og interne stimuleringsstipend i tråd med kompetanseplan for forsking.
Tiltak 3: Styrka konkurranseevne om søkbare forskingsmidlar ved å opprette ei vitskapleg referansegruppe (Scientific Advisory Board) med representantar frå universiteta, høgskulen og helseføretak i regionen
Tiltak 4: Utgreie nødvendige støttefunksjonar for forsking og innovasjon så som juridiske-. HR- og økonomitenester
Helse Fonna skal synleggjere og legge til rette for forskarkarriere i føretaket.
Kompetente forskarar bør ivaretakast, for eksempel i utlyste deltidsstillingar. Det er behov for fleksible overgangsordningar, som stimuleringsstipend, for å halde på forskingskompetansen.
Det bør leggast til rette for dobbeltkompetanseløp i form av parallell forskingsutdanning (PhD) og klinisk spesialisering for legar og psykologar.
Mål: Etablere føreseielege rammer for forskingskarriere i føretaket
Tiltak 1: Årlege medarbeidarsamtalar med fokus på karriereplanlegging for stipendiatar og etablerte forskarar
Tiltak 2: Forskings- og innovasjonsavdelinga skal ta initiativ til karriereplanlegging saman med klinikkdirektør etter avlagte doktorgrader
Tiltak 3: Legge til rette for delte stillingar mellom forsking og klinisk verksemd
I strategiperioden 2016-2020 blei det oppretta to tematiske forskingsgrupper; indremedisin og eldremedisin. Dei er verkemiddel for å styrke forsking og forskingsmiljø innan prioriterte områder. Oppretting av nye forskingsgrupper skal ta utgangspunkt i forskingstema og metodikk der føretaket har kompetanse, og innan prioriterte kliniske område.
Mål: Vidareutvikle tematiske forskingsgrupper
Tiltak 1: Utlyse stimuleringsstipend knytt til forskingssvake område
Tiltak 2: Utlyse stimuleringsstipend knytt til tematiske forskingsgrupper
Tiltak 3: Etablere ei ny tematisk forskingsgruppe i strategiperioden med utgangspunkt i kartlegging av behov, nytte og kompetanse i helseføretaket
Helse Fonna skal drive planlagt og aktiv forskingsformidling internt og eksternt for å styrke omdømet og tilliten i befolkninga, og skape engasjement og ein sterk kunnskapskultur blant medarbeidarane.
Synleggjering av forskingsaktiviteten, satsingsområde og forskingsgrupper vil bidra til å styrke rekrutteringa av forskar-, brukar- og klinisk kompetanse.
Formidling skal vere ein integrert del av arbeidet til forskarane. Forskingskompetansen og resultata av forsking og innovasjon internt i Helse Fonna skal synleggjerast i dei kliniske avdelingane. Dette skal bidra til fagutvikling og sørgje for at ny kunnskap blir tatt i bruk raskt. Det skal også bidra til intern rekruttering til forsking. Forskingsformidling skal utgjere ein større del av innhaldet som blir delt i Helse Fonna sine kanalar. Samarbeid med kommunikasjonsavdelinga som støtte og rådgivarar for synleggjering av forskingsaktivitet i føretaket skal vidareutviklast.
Forskarane skal publisere i fagfellevurderte tidsskrift, delta på konferansar og seminar og vere synlege i media og fagpresse.
Mål: Formidling av forskingsresultat i pågåande forskings- og innovasjonsprosjekt
Tiltak 1: Legge til rette for Open Access i alle forskingsprosjekt
Tiltak 2: Faste månadlege møte mellom kommunikasjonsavdelinga og avdeling for forsking og innovasjon
Tiltak 3: Avdeling for forsking og innovasjon skal opprette ein intern forskingspris som skal delast ut årleg
Mål: Formidlingskompetanse hos forskarane
Tiltak 1: Kompetansehevande tiltak innan forskingsformidling skal vere på agendaen i det årlege forskingsseminaret
Tiltak 2: Jamleg tilby kurs i forskingsformidling
Samarbeid
Alle forskings- og innovasjonsprosjekt skal bidra til betre helsetenester og må derfor involvere aktuelle brukarar av resultata. Det er fire brukargrupper som utgjer hovudtyngda i forsking og innovasjon: Pasientar og pårørande, helsepersonell, befolkninga generelt, næringsliv og styresmakter
Brukarar har gjennom sine erfaringar ein kompetanse som bidrar til å auka forskinga sin relevans, kvalitet og forståing av datamateriale og formidling av forskinga.
Mål: Aktiv brukarmedverknad i alle forskings- og innovasjonsprosjekt
Tiltak 1: Vidareføre og utvikle brukarpanelet for forsking og innovasjon, og vidareutvikle samarbeidet med brukarorganisasjonane
Tiltak 2: Sikre kompetanse ved å legge til rette for kurs/e-læring i brukarmedverknad for forskarar og brukarar
Tiltak 3: Krav om gjennomført e-læringskurs for nye forskarar og medforskarar
Tiltak 4: Årleg rapportering av forsking og innovasjon til brukarutvalet
Universitet, universitetssjukehus og høgskular er viktige samarbeidspartnarar for å utvikle forsking og innovasjon av høg fagleg kvalitet. Helse Fonna må ha eit tett samarbeid med universitet og høgskular, både for grunnutdanning av helsepersonell og utdanning av forskarar gjennom doktorgradsprogram.
I planperioden skal Helse Fonna inngå samarbeidsavtalar med Høgskulen på Vestlandet om forsking og innovasjon. I prosjektet «Vestlandslegen» ved medisinsk fakultet ved Universitetet i Bergen samarbeider Helse Fonna om vidareutvikling av utdannings- og forskingssamarbeid. Det skal også vere eit samarbeid med Universitetet i Bergen om kvalifisering til professorkompetanse for våre tilsette.
Mål: Etablerte rammer for samarbeid med universitet og høgskular
Tiltak 1: Inngå nivå 2-avtale om institusjonelt samarbeid om forsking og innovasjon med Høgskulen på Vestlandet
Tiltak 2: Delta aktivt i planlegginga av «Vestlandslegen» med Universitetet i Bergen
Tiltak 3: Tilrettelegging og samarbeid med universitetet for kvalifisering til professorkompetanse
Tiltak 4: Målretta samarbeid med universitets- og høgskulesektoren om delte stillingar og bi-stillingar for medarbeidarar med doktorgradskompetanse
I dei neste fem åra skal Helse Fonna styrke sin posisjon som forskingsinstitusjon gjennom auka samarbeid internt med klinikk og brukargrupper, eksternt med akademiske miljø og andre føretak, samt lokalt med primærhelsetenesta og næringslivet. Vi skal utnytte dei eksisterande fortrinna vi har med godt samarbeid med brukarorganisasjonar, god tilgang på store pasientgrupper. I planperioden skal føretaket betre samarbeidet med kommunane i tråd med nasjonal helse- og sjukehusplan.
Mål: Tilrettelagte rammer for forskings- og innovasjonssamarbeid mellom kommunar, næringsliv og helseføretak
Tiltak 1: Inngå avtalar om samarbeid om forsking og innovasjon i tråd med nasjonale føringar for helsefellesskap
Tiltak 2: Årlege møtepunkt/forskingsnettverk for primær- og spesialisthelseteneste i opptaksområdet der forskarar, klinikarar, leiarar og brukarrepresentantar møter for å utveksle idear, kunnskap og forskingsresultat
Tiltak 3: Møtepunkt for private og offentlege forskingsaktørar i regionen for idémyldring og mogleg samarbeid
